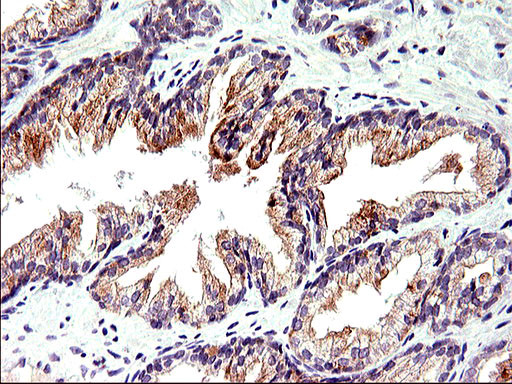
TOLLIP Antibody in Immunohistochemistry (Paraffin) (IHC (P))

Search
OriGene
TOLLIP Monoclonal Antibody (OTI2A4), TrueMAB™
{{$productOrderCtrl.translations['antibody.pdp.commerceCard.promotion.promotions']}}
{{$productOrderCtrl.translations['antibody.pdp.commerceCard.promotion.viewpromo']}}
{{$productOrderCtrl.translations['antibody.pdp.commerceCard.promotion.promocode']}}: {{promo.promoCode}} {{promo.promoTitle}} {{promo.promoDescription}}. {{$productOrderCtrl.translations['antibody.pdp.commerceCard.promotion.learnmore']}}
产品信息
CF507039
宿主/亚型
分类
类型
克隆号
抗原
偶联物
形式
浓度
规格
保存条件
运输条件
产品详细信息
For reconstitution, we recommend adding 100 µL distilled water to a final antibody concentration of about 1 mg/mL. To use this carrier-free antibody for conjugation experiments, we strongly recommend performing another round of desalting. (Zeba Spin Desalting Columns, 7KMWCO, 0.5 mL, Product # 89882)
靶标信息
Toll-like receptors (TLRs) are evolutionarily conserved pattern-recognition molecules resembling the toll proteins that mediate antimicrobial responses in Drosophila. These proteins recognize different microbial products during infection and serve as an important link between the innate and adaptive immune responses. The TLRs act through adaptor molecules to activate various kinases and transcription factors so the organism can respond to potential infection. These adaptor molecules include TOLLIP, MyD88, and TRIF. TOLLIP associates directly with TLR2 and TLR 4, acting as an inhibitor to TLR activation. This negative regulation of TLR signaling may serve to limit the production of proinflammatory mediators during infection and inflammation.
仅用于科研。不用于诊断过程。未经明确授权不得转售。